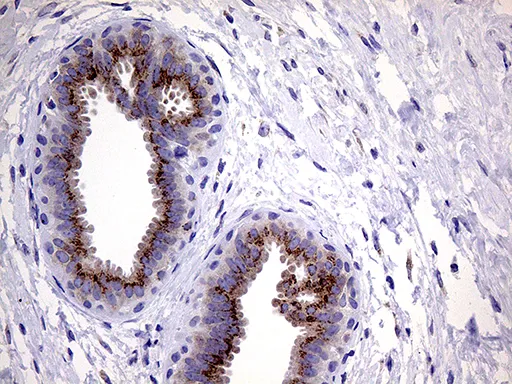

中文 | English

中文
MYOT mouse monoclonal antibody,clone OTI5E11
Cat Number: GAM920686
MYOT mouse monoclonal antibody,clone OTI5E11
Species Reactivity:
HumanMouseRat
Applications:
IHCWB
$ 169
/ 50μl
In Stock
50μl100μl
Description
Recommended Dilution
Product Features
Species Reactivity
HumanMouseRat
Applications
IHCWB
Purification method
Affinity Purification
Clone name
OTI5E11
Immunogen
Full length human recombiant protein of human MYOT (NP_006781) produced in E.coli.
Host species
Mouse
Clonality
Monoclonal
Background
This gene encodes a cystoskeletal protein which plays a significant role in the stability of thin filaments during muscle contraction. This protein binds F-actin, crosslinks actin filaments, and prevents latrunculin A-induced filament disassembly. Mutations in this gene have been associated with limb-girdle muscular dystrophy and myofibrillar myopathies. Several alternatively spliced transcript variants of this gene have been described, but the full-length nature of some of these variants has not been determined. [provided by RefSeq, Oct 2008]
Calculated molecular weight
55.2 kDa
Uniprot
Q9UBF9
Isotype
IgG1
Alias
Myotilin

Cat Number: GAM920686
MYOT mouse monoclonal antibody,clone OTI5E11
Species Reactivity:
HumanMouseRat
Applications:
IHCWB
$ 169
/ 50μl
In Stock
50μl100μl
Description
Recommended Dilution
Product Features
Species Reactivity
HumanMouseRat
Applications
IHCWB
Purification method
Affinity Purification
Clone name
OTI5E11
Immunogen
Full length human recombiant protein of human MYOT (NP_006781) produced in E.coli.
Host species
Mouse
Clonality
Monoclonal
Background
This gene encodes a cystoskeletal protein which plays a significant role in the stability of thin filaments during muscle contraction. This protein binds F-actin, crosslinks actin filaments, and prevents latrunculin A-induced filament disassembly. Mutations in this gene have been associated with limb-girdle muscular dystrophy and myofibrillar myopathies. Several alternatively spliced transcript variants of this gene have been described, but the full-length nature of some of these variants has not been determined. [provided by RefSeq, Oct 2008]
Calculated molecular weight
55.2 kDa
Uniprot
Q9UBF9
Isotype
IgG1
Alias
Myotilin

扫码添加微信客服
